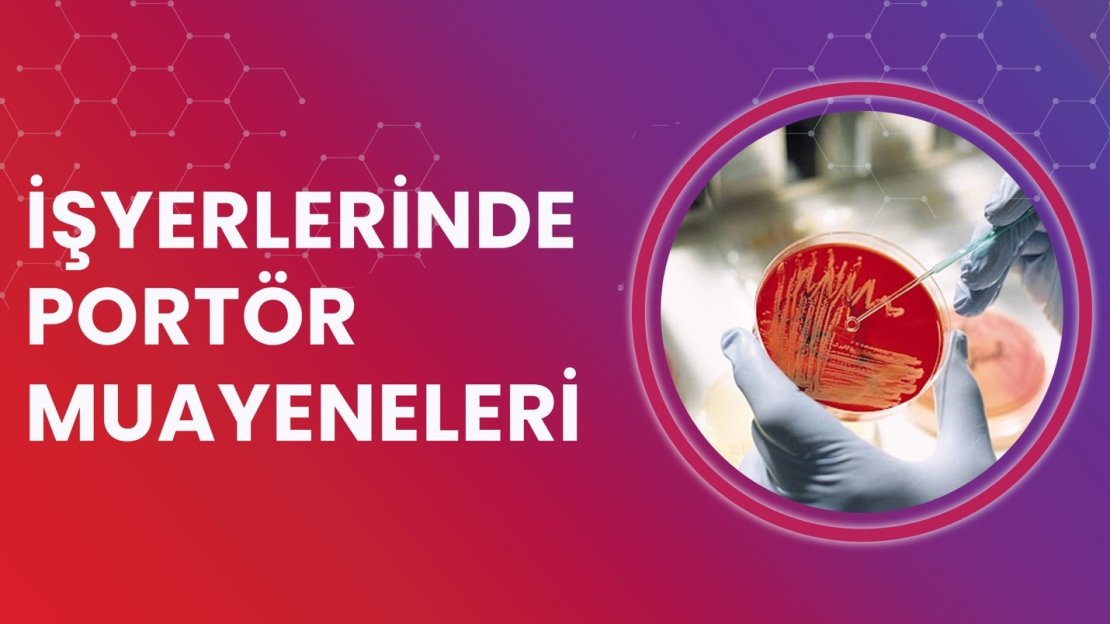
Mobil Portör Muayenesi

Modern Laboratuvar Ekipmanlarımız
Akredite laboratuvarlarımızda, en son teknoloji cihazlarla hızlı ve güvenilir test sonuçları sunuyoruz.
- Tam otomatik biyokimya analizörleri
- Hematoloji cihazları
- Mikrobiyoloji laboratuvarı
- Seroloji test sistemleri
- Toksikoloji analizleri